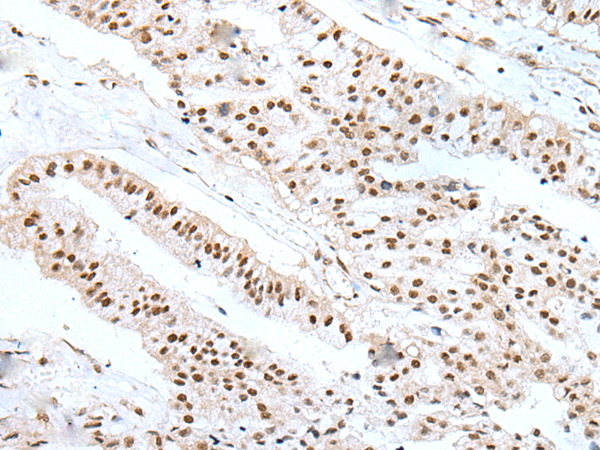

中文名稱:兔抗WTAP多克隆抗體
英文名稱: Anti-WTAP rabbit polyclonal antibody
別 名: Mum2
相關(guān)類別: 一抗
儲 存: 冷凍(-20℃)
宿 主: Rabbit
抗 原: WTAP
反應(yīng)種屬: Human, Mouse
標(biāo) 記 物: Unconjugate
克隆類型: rabbit polyclonal
技術(shù)規(guī)格
|
Background: |
The Wilms tumor suppressor gene WT1 appears to play a role in both transcriptional and posttranscriptional regulation of certain cellular genes. This gene encodes a WT1-associating protein, which is a ubiquitously expressed nuclear protein. Like WT1 protein, this protein is localized throughout the nucleoplasm as well as in speckles and partially colocalizes with splicing factors. Alternative splicing of this gene results in several transcript variants encoding three different isoforms. |
|
Applications: |
ELISA, IHC |
|
Name of antibody: |
WTAP |
|
Immunogen: |
Full length fusion protein |
|
Full name: |
Wilms tumor 1 associated protein |
|
Synonyms: |
Mum2 |
|
SwissProt: |
Q15007 |
|
ELISA Recommended dilution: |
5000-10000 |
|
IHC positive control: |
Human liver cancer and human brain |
|
IHC Recommend dilution: |
25-100 |

購物車
購物車 幫助
幫助
 021-54845833/15800441009
021-54845833/15800441009
